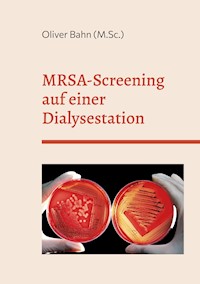
MRSA-Screening auf einer Dialysestation - Oliver Bahn - E-Book

Kategorien
- Alle
- Krimi
- Fantasy und Science-Fiction
- Gesellschafts- und Liebesromane
- Für Kinder und Jugendliche
- Geisteswissenschaft
- Fremdsprachen
- Sachliteratur, Reportagen, Biografien
- Wissenschaft und neue Technologien
- Ratgeber
- Abenteuer, Thriller, Horror
- Fachliteratur
- Lebensstil
- Bildung
- Poesie und Drama
- Religion und Spiritualität
- Erotik
- Kostenlos
Sortieren nach: